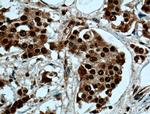
NSUN2 Antibody in Immunohistochemistry (Paraffin) (IHC (P))
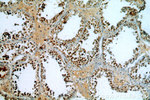
NSUN2 Antibody in Immunohistochemistry (Paraffin) (IHC (P))

Search
Proteintech
NSUN2 Polyclonal Antibody
{{$productOrderCtrl.translations['antibody.pdp.commerceCard.promotion.promotions']}}
{{$productOrderCtrl.translations['antibody.pdp.commerceCard.promotion.viewpromo']}}
{{$productOrderCtrl.translations['antibody.pdp.commerceCard.promotion.promocode']}}: {{promo.promoCode}} {{promo.promoTitle}} {{promo.promoDescription}}. {{$productOrderCtrl.translations['antibody.pdp.commerceCard.promotion.learnmore']}}
产品信息
20854-1-AP
种属反应
已发表种属
宿主/亚型
分类
类型
抗原
偶联物
形式
浓度
规格
纯化类型
保存液
内含物
保存条件
运输条件
产品详细信息
Immunogen sequence: HHQNTGGFF VAVLVKKSSM PWNKRQPKLQ GKSAETREST QLSPADLTEG KPTDPSKLES PSFTGTGDTE IAHATEDLEN NGSKKDGVCG PPPSKKMKLF GFKEDPFVFI PEDDPLFPPI EKFYALDPSF PRMNLLTRTT EGKKRQLYMV SKELRNVLLN NSEKMKVINT GIKVWCRNNS GEEFDCAFRL AQEGIYTLYP FINSRIITVS MEDVKILLTQ ENPFFRKLSS ETYSQAKDLA KGSIVLKYEP DSANPDALQC PIVLCGWRGK ASIRTFVPKN ERLHYLRMMG LEVLGEKKKE GVILTNESAA STGQPDNDVT EGQRAGEPNS PDAEEANSPD VTAGCDPAGV HPPR (415-767 aa encoded by B C001041)
靶标信息
NSUN2 encodes a methyltransferase that catalyzes the intron-dependent formation of 5-methylcytosine at C34 of tRNA-leu(CAA). Maturation of cytoplasmic tRNAs includes splicing of introns, which are located 1 nucleotide 3-prime from the anticodon in all intron-containing tRNA genes. In tRNA-leu(CAA), the first position of the anticodon, C34, is converted to 5-methylcytosine, a modification necessary to stabilize the anticodon-codon pairing and correctly translate the mRNA. Mutations of NSUN2 result in autosomal recessive 5 mental retardation (MRT5).
仅用于科研。不用于诊断过程。未经明确授权不得转售。
生物信息学
蛋白别名: 5-methycytoisine methyltransferase; hTrm4; Misu; mRNA cytosine C(5)-methyltransferase; Myc-induced SUN domain-containing protein; Myc-induced SUN-domain-containing protein; NOL1/NOP2/Sun domain family member 2; NOL1/NOP2/Sun domain family, member 2; NOP2/Sun domain family, member 2; NOP2/Sun RNA methyltransferase family member 2; RNA cytosine C(5)-methyltransferase NSUN2; Substrate of AIM1/Aurora kinase B; tRNA (cytosine(34)-C(5))-methyltransferase; tRNA (cytosine-5-)-methyltransferase NSUN2; tRNA cytosine C(5)-methyltransferase; tRNA methyltransferase 4 homolog; unnamed protein product
基因别名: MISU; MRT5; NSUN2; SAKI; TRM4
UniProt ID: (Human) Q08J23
Entrez Gene ID: (Human) 54888